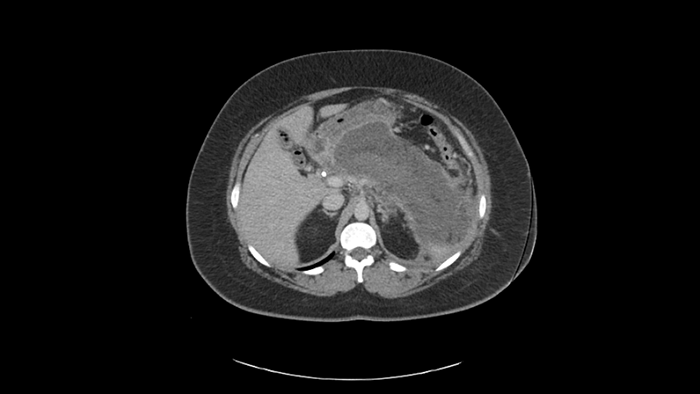
CT scan

Chronic pancreatitis case: Paul

Discover a patient’s walled off pancreatic necrosis journey developed in collaboration with clinician experts.
Start of symptoms
Paul Willemse, a 33-year old man, was admitted to the emergency room for assessment, following three days of abdominal pain, fever, loss of appetite, nausea, and vomiting.
His ER laboratory results demonstrated:
Elevated white blood cell count
His CT scan results showed:
Severe necrotizing pancreatitis
Peripancreatic fluid largely replacing the body and tail of the gland
Symptomatic pancreatic pseudocysts may be treated surgically, percutaneously, or endoscopically. However, surgery is associated with high rates of morbidity (7%–37%) and mortality (6%). Percutaneous drainage is associated with increased infection risk and fistula formation.1
On the other hand, another recent retrospective comparative study, including 133 patients with WON treated with multiple plastic stents (n = 61) or LAMSs (n = 72), showed a superior clinical success rate for LAMSs (94 % vs. 74%; P < 0.05).2
Paul’s treatment

1. WON formation
Due to the acute nature of Paul’s clinical presentation, the gastroenterologist decided to delay the treatment. This was done to allow the necrotic area to mature into a walled-off pancreatic necrosis (WON).

Revised Atlanta Classification: An expert consensus panel reclassified how Pancreatic Fluid Collection (PFC) are defined, considering both the length of time the fluid collection has been present and its content.3,4
2. EUS-guided transluminal Lumen Apposing Metal Stent placement
A CT scan was performed six weeks later showing WON formation with liquefaction, as well as good apposition to the posterior wall of the stomach. The patient was referred for EUS-guided transluminal AXIOS™ Lumen Apposing Metal Stent (LAMS) placement/cyst gastrostomy.
The Hot AXIOS™ Stent and Electrocautery Enhanced Delivery System
The AXIOS Stent is specifically designed for drainage of pancreatic pseudocysts and is intended to overcome the limitations of other drainage options.


3. Lumen-apposing metal stent (LAMS) deployment
EUS with Doppler revealed a large wall of necrosis measuring 20cm. The lesion had a thick wall and contained solid debris with copious amounts of liquid, common for WON with liquefaction.
The stent creates an anastomotic conduit between the lumens of the pancreas and GI tract, enabling large fluid collection and WON to be drained. The Hot AXIOS integrates an electrocautery delivery system that eliminates the need to use a needle to puncture the pancreatic lumen.

Using the AXIOS Stent, the WON was accessed via a transgastric route. A 20mm wide and 10mm long AXIOS™ LAMS was deployed across the gastric wall.

4. Pancreatic fluid collection drainage
Approximately 1L of purulent content, mixed with solid and liquid PFC drained from the WON to the stomach. The stent was left in situ.

The larger 20mm AXIOS™ Stent was ideal for this patient as it allowed rapid drainage of both solid and liquid contents and will greatly facilitate endoscopic necrosectomy if needed in the future.
The end of Paul’s discomfort

The patient tolerated the procedure well without difficulty or any adverse events. He was given a prescription for oral antibiotics and allowed to return home with instructions to follow up with an outpatient appointment.
















